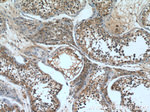
RAE1 Antibody in Immunohistochemistry (Paraffin) (IHC (P))

Search
Proteintech
RAE1 Polyclonal Antibody
{{$productOrderCtrl.translations['antibody.pdp.commerceCard.promotion.promotions']}}
{{$productOrderCtrl.translations['antibody.pdp.commerceCard.promotion.viewpromo']}}
{{$productOrderCtrl.translations['antibody.pdp.commerceCard.promotion.promocode']}}: {{promo.promoCode}} {{promo.promoTitle}} {{promo.promoDescription}}. {{$productOrderCtrl.translations['antibody.pdp.commerceCard.promotion.learnmore']}}
产品信息
20491-1-AP
种属反应
宿主/亚型
分类
类型
抗原
偶联物
形式
浓度
规格
纯化类型
保存液
内含物
保存条件
运输条件
产品详细信息
Immunogen sequence: MSLFGTTSG FGTSGTSMFG SATTDNHNPM KDIEVTSSPD DSIGCLSFSP PTLPGNFLIA GSWANDVRCW EVQDSGQTIP KAQQMHTGPV LDVCWSDDGS KVFTASCDKT AKMWDLSSNQ AIQIAQHDAP VKTIHWIKAP NYSCVMTGSW DKTLKFWDTR SSNPMMVLQL PERCYCADVI YPMAVVATAE RGLIVYQLEN QPSEFRRIES PLKHQHRCVA IFKDKQNKPT GFALGSIEGR VAIHYINPPN PAKDNFTFKC HRSNGTNTSA PQDIYAVNGI AFHPVHGTLA TVGSDGRFSF WDKDARTKLK TSEQLDQPIS ACCFNHNGNI FAYASSYDWS KGHEFYNPQK KNYIFLRNAA EELKPRNKK (1-368 aa encoded by BC103754 )
靶标信息
Mutations in the Schizosaccharomyces pombe Rae1 and Saccharomyces cerevisiae Gle2 genes have been shown to result in accumulation of poly-containing mRNA in the nucleus, suggesting that the encoded proteins are involved in RNA export. The protein encoded by this gene is a homolog of yeast Rae1. It contains four WD40 motifs, and has been shown to localize to distinct foci in the nucleoplasm, to the nuclear rim, and to meshwork-like structures throughout the cytoplasm. This gene is thought to be involved in nucleocytoplasmic transport, and in directly or indirectly attaching cytoplasmic mRNPs to the cytoskeleton. Alternatively spliced transcript variants encoding the same protein have been found for this gene.
仅用于科研。不用于诊断过程。未经明确授权不得转售。
生物信息学
蛋白别名: FLJ30608; HGNC:9828; homolog of yeast Rae1 (Bharathi) mRNA-associated protein of 41 kDa (Kraemer); MGC117333; MGC126076; MGC126077; MIG14; migration-inducing gene 14; mRNA export factor; mRNA export factor RAE1; mRNA export protein; mRNA-associated protein MRNP 41; mRNA-binding protein, 41-kD; OTTHUMP00000166110; Rae1; Rae1 protein homolog; RAE1 RNA export 1 homolog; RAE1-like protein; RP4-800J21.2; unnamed protein product
基因别名: dJ481F12.3; dJ800J21.1; Gle2; MIG14; Mnrp41; MRNP41; RAE1
UniProt ID: (Human) P78406
Entrez Gene ID: (Human) 8480